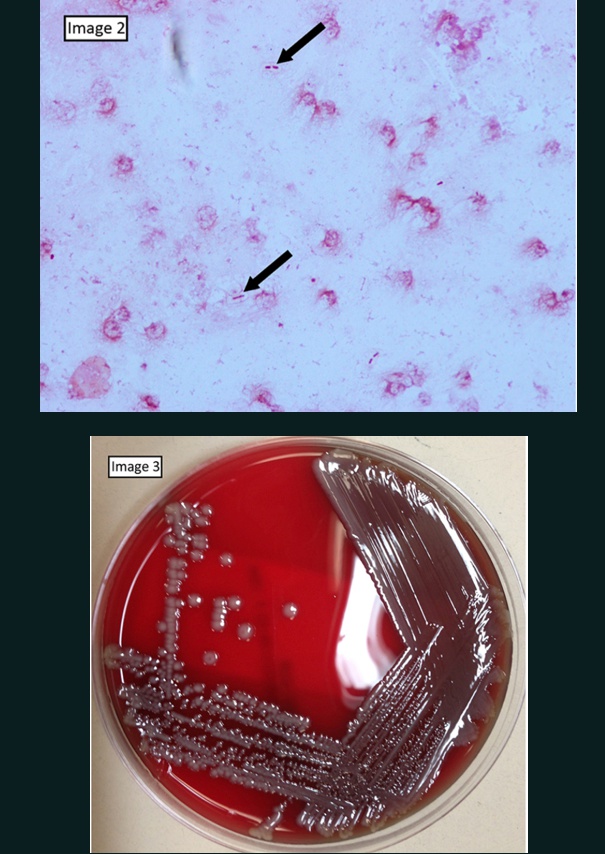

04 Gm Negative Enteric Bacilli
Klebsiella, Enterobacter, Serratia
_..

O2 mask: Pneumonia
bag of urine: Urinary tract infection
Pills on ground: Multidrug resistant, treatment with carbapenem
hospital room: nosocomial infections, thus multi drug resistance
milk: Lactose fermenter
pink milk cartoon: Pink on MacConkey Agar
Enterobacter cloacae
_..

enterodactyl
flying: motile
Serratia marcescens
_..

triceratops
charging with arm up: Motile
red color: Produces red pigment on culture
catalase positive
Klebsiella pneumoniae
_..

ankylosaurus with clubbed tail/ kleb tail
mucous on back: polysaccharide capsule
NH3 bottle spraying kleb: Urease positive
all 4 feet: Immotile
clear zone and thick capsule
_..

3 A's: Alcoholics, abscesses, aspiration (started from aspiration)
knocked over jar of currant jelly: "Currant" jelly sputum
Xray: Cavitary lesion, may look like TB
Liver abscess via ascending cholangitis
The hallmark of Klebsiella pneumonia is a thick, mucoid, blood-tinged sputum (currant jelly sputum) and lung tissue necrosis with early abscess formation.
Salmonella
_..

macrophage cage: Facultative intracellular within macrophages
fish tail floppy: Salmonella is motile
lemon cut: Acid-labile
black plate: H2S positive, black colonies on Hektoen Agar plate
fish bone: Osteomyelitis
capsule: vi Capsule, inhibit phagocytosis
_..

flower: Fluoroquinolones treatment (ie Cipro)
_..

syringe: Live attenuated vaccine
Enteritidis
_..

left chicken: The reservoir for Salmonella enteritidis is the chicken
match: Inflammatory diarrhea
syringe bulb: Type III secretion system
Typhi
_..

right: Salmonella typhi
sickle: In Sickle Cell disease
seagull: Salmonella typhi in the gallbladder of chronic carriers
cook drape: Typhoid Mary
drape: Rose colored macules
Green pea: "Pea soup" diarrhea

Shigella
_..

standing on acid: Acid stable
green shirt: Green colonies on Hektoen agar
chained to stone: Immotile
_..

actin projectile: Use of actin filaments
M: Invasion of M cells
_..

Flame all around: Inflammatory diarrhea
Red stool: blood in stool
HUS:
whip: Glomerular damage first
plates: thrombosis with platelet, drop in platelet counts
popped balloon: platelet aggregation lyse RBC, Red blood cell hemolysis
young kid: HUS common in young children
_..

60a timer: Toxin binds to 60S subunit of ribosomes
syringe with bulb: Type III Secretion System
E. Coli
_..

cat: Catalase positive
milk bottle: Lactose fermenter
pink milk bottle: Pink on MacConkey Agar
capsule with cake: Encapsulated
K cake: K Antigen
green drink holder: Green on EMB agar
type III secretion
_..

milkshake with red strawberry: leading cause of sepsis via LPS
hair bow: Fimbriae, pili like, cause for UTI
UTI cup with #1: Most common cause of UTI
neonate with helmet: Neonatal meningitis
neonate points to cake: Only if it has K antigen
EHEC
_..

shiga toy: Shiga-like toxin can cause HUS
Only $1.57: O157:H7 antigen is associated with outbreaks
hamburger: Transmitted by eating undercooked meat
ketchup on table and red stool: Bloody diarrhea
sorbitol bottle: Does NOT ferment sorbitol
balloon string: Damages endothelial cells in the glomerulus
plates: Platelet aggregation follows and decrease in platelet count
Popped balloon: Red blood cell hemolysis via the thrombosis
ETEC
_..

traveller truck: Traveler's diarrhea
water truck: Transmitted via water
LA: L = Labile, A = cAMP
SG: S= Stable G = cGMP
water truck: Watery diarrhea
Yersinia
Yersinia Enterolitica
_..

English terrier: yersinia enterolitica
ice on window: Resistant to cold temperatures
Safety pin: Bipolar staining, sometimes described as having a safety pin appearance
glass capsule: Encapsulated

_..

poop in cage: Y. enterocolitica transmitted through puppy feces
milk bottle: May be transmitted through contaminated milk products
baby: Toddlers are commonly affected by Y. enterocolitica
_..

red stool: bloody stool
right abdomen toddler : Infection can mimic appendicitis symptoms
Yersinia Pestis
_..

Pink color: Gram negative organism
Rodents in cage: Prairie dogs main reservoir in United States
flea sign: Transmitted by flea bites
_..

sai: Streptomycin (with tetracycline) for treatment
mouse wheel: Tetracyclines (with streptomycin) for treatment
_..

syringe bulb: Yops (yersinia outer protein) secreted via type III secretion systems, stops phagocytosis
_..

guy with buboes: Characteristic buboes form on skin
Uncontrolled spread can cause organ abscess, cutaneous hemorrhage, and tissue necrosis
_..

killed vaccine sign: Killed vaccine can be used to prevent transmission
Campylobacteria Jejuni
_..

curved moustache: Curved/spiral gram negative rod
flame: Grows at 42 degrees C
chicken roasted: Poultry reservoir. Can be transmitted from domestic animals (pet dog)
ring: Oxidase positive
_..

red stool: Causes bloody diarrhea
bear cub invading cooler: Invasive, bacteremia, sepsis
slapping knee: Reactive arthritis, seronegative
bear playing with sausages: Guillain-Barre syndrome - Ascending paralysis
Vibrio
_..

blue ring: Oxidase positive
comma mustache: Comma shaped
red boat: Gram negative
lemon sliced: Acid labile because grows on alkaline media
base camp map: Grows on alkaline media
_..

boat attached: Fimbrae attachment, does not invade
Base camp map: Increases cAMP
Gs bottle: Toxin activates Gs pathway and cAMP, increase water secretion
_..

bathroom: Fecal-oral transmission
rice farms: Rice water stools
water: Watery diarrhea
general drinking water: Oral rehydration therapy
_..

Vibrio vulnificus/parahemolyticus: oysters on plate, contaminated sea food
Helicobacter
_..

ammonium bottle: Urease positive, splits urea into ammonia and CO2, reduce acidity for invasion (urease breath test)
helicopter blade: Motile, spins around with flagellum
curved mustache: Curved/spiral gram negative rod
blue ring: Oxidase positivex
silver headphones: silver stain
catalase positive
_..

bullet holes and duodenum letters: Duodenal ulcers
crab: Increased risk of gastric adenocarcinoma
pile of tissues with mucous: Mucosa associated lymphoid tissues (MALT)
_..

gasoline pump: Proton Pump Inhibitor (PPI)
ammo box: Amoxicillin
keep clear crows: Clarithomycin
​
Pseudomonas
_..

cat: Catalase positive
red bathtub: Gram negative rod
blue ring: Oxidase positive
glass capsule: Encapsulated
grapes on table: Produces fruity grape odor
air bellow: Obligate aerobe
water in red tub: Thrives in aquatic environment
blue/green residue: Produces blue-green pigment (from pyocyanin and pyoverdin)
motile
type 3 secretion
_..

Nurse coughing and pouring Cl water: Nosocomial pneumonia and respiratory failure in cystic fibrosis patients due to Cl mutation
fish bone next to candy and mortar: Osteomyelitis in diabetics (traumatic injury) and IV drug users (directly introduce via needles)
maid on fire: Infection associated with burn patients
chamber pot: Nosocomial urinary tract infections
Hot tub folliculitis: red, itching, pustular folliculitis association with hot tub
dog with black spot: Ecthyma gangrenosum - black necrotic lesions on skin (from toxins)
Maid listening with trumpet outside ear: Otitis externa. Swimmer's ear

_..

Guy wearing green with bow: Toxin inactivates EF-2 by ribosylation (Same mechanism as Diphtheria toxin)
_..

Piper: Piperacillin for treatment
flower: Fluoroquinolones, great for UTI
sai: Aminoglycosides, good with tetracycline
Proteus mirabilis
_..

red: gm negative
NH3: Urease positive, makes ammonium/CO2, alkaline environment, responsible for struvite stones precipation
octopus: Swarming motility when plated
Fish all around: Fishy odor
_..

horn of stag: Forms staghorn calculi in renal stones
Stone in hand: Alkaline environment can cause struvite stone production
Guy urinating: May cause UTI

_..

Eggs: Treat with sulfonamides
Last updated
Was this helpful?